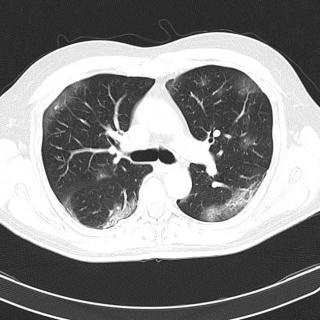

Рентгенограмма, КТ, МРТ при остеорадионекрозе челюсти
Добавил пользователь Алексей Ф. Обновлено: 01.01.2026
а) Терминология:
1. Аббревиатура:
• Остеорадионекроз (ОРН)
2. Определение:
• Некроз кости и нарушение заживления как осложнение лучевой терапии
б) Визуализация:
1. Общая характеристика:
• Лучший диагностический критерий:
о Смешанные (литические и склеротические) изменения костей после облучения:
- Изъязвление кожи или слизистой оболочки с обнажением кости
- Остеорадионекроз часто осложняется переломом, а также инфицированием
- Отсутствие дискретного мягкотканного объемного образования помогает отличить остеорадионекроз от рецидива опухоли
• Локализация:
о Голова и шея: преимущественно челюсти и основание черепа:
- Нижняя челюсть >> верхняя челюсть и другие кости лицевого скелета
- Височная и клиновидная кость основания черепа
- Также описан остеорадионекроз лобной и подъязычной кости
• Размер:
о Поражение может быть местным или распространенным
о Может сочетаться с некрозом окружающих мягких тканей
2. Рекомендации по визуализации:
• Лучший метод диагностики:
о КТ в костном окне
о Диффузные воспалительные изменения мягких тканей в отсутствие объемного образования
• Выбор протокола:
о Тонкосрезовая КТ с использованием костного алгоритма с реформатированием в корональной и сагиттальной плоскости:
- Мультипланарное реформатирование используется для планирования операции, в т.ч. возможного реконструктивного вмешательства
- Необходимо реформатирование в сагиттальной плоскости (под углом) параллельно углу нижней челюсти
о КТ с контрастным усилением при клиническом подозрении на присоединение инфекции или рецидив опухоли
3. Рентгенография:
• Экстраоральная рентгенография:
о Смешанные (литические и склеротические) изменения костей
о Распространенность поражения и деструкции часто недооцениваются на рентгенограммах

(Слева) На панорамной дентальной рентгенограмме у пациента, которому ранее было выполнено оперативное вмешательство и осуществлялась лучевая терапия полости рта, определяется диффузное утолщение и остеосклероз нижней челюсти, утолщение и деформация трабекул, нарушение дифференцировки кортикальной пластинки в области нижнего края нижней челюсти слева.
(Справа) При сагиттальной КТ (по углом) определяются множественные неоднородные «просветления» в кости, нарушение целостности кортикального слоя, утолщение и склероз трабекул и кортикальной пластинки. Обратите внимание на глубокую «лунку», оставшуюся после экстракции моляра. Определяется также фрагментация венечного отростка и шейки мыщелка.
4. КТ при остеорадионекрозе челюсти:
• КТ с контрастным усилением
о Отек и индурация мягких тканей даже в отсутствие суперинфекции
о При присоединении инфекции патологическое накопление контраста или появление небольших абсцессов
о Часто также возникают свищи, открывающиеся в кожу
• КТ в костном окне:
о Нарушение целостности кортикального слоя на фоне смешанного (литического и склеротического) компонента:
- Разрушение трабекул приводит к появлению изменений литического характера; затем происходит склерозирование
о Часто обнаруживаются секвестрированные спикулы костной ткани, костные фрагменты
о В патологически измененной нижней челюсти и в расположенных поблизости некротических тканях часто присутствуют пузырьки газа
о Может обнаруживаться патологический перелом, возникновение которого ускоряет появление симптомов
• ПЭТ/КТ:
о Выраженное накопление радиофармпрепарата в зоне ОРН:
- Вероятно, обусловленное воспалительным компонентом
о Для обнаружения рецидива опухоли результаты ПЭТ важно интерпретировать совместно с результатами КТ с контрастным усилением
о Даже если ПЭТ/КТ и КТ с контрастным усилением свидетельствуют о рецидиве опухоли, обнажение кости со стороны полости рта или кожи однозначно свидетельствует в пользу остеорадионекроза
5. МРТ при остеорадионекрозе челюсти:
• Т1ВИ:
о Диффузный гипоинтенсивный сигнал в костном мозге
о Может также обнаруживаться нарушение целостности кортикального слоя
• Т2ВИ:
о Диффузный гиперинтенсивный сигнал в костном мозге
о Возможно наличие признаков отека окружающих тканей
• Т1ВИ FS С+:
о Диффузное контрастное усиление костного мозга
о Отсутствие солидного объемного образования поблизости

(Слева) При аксиальной КТ в костном окне у пациента, получавшего лучевую терапию по поводу плоскоклеточного рака носовой перегородки, визуализируется очаг литического характера в передних отделах верхней челюсти, представляющий собой треугольный участок деструкции костной ткани.
(Справа) При аксиальной КТ в костном окне у другого пациента определяются признаки выполненной резекции неба справа, а также изменения смешанного (склеротического и литического) характера в верхней челюсти слева, которая подвергалась облучению. Верхняя челюсть является относительно устойчивой к ионизирующему излучению, в ней редко возникает остеорадионекроз. Лучевые признаки идентичны таковым при поражении других костей лицевого скелета и основания черепа.
в) Дифференциальная диагностика остеорадионекроза челюсти:
1. Остеомиелит:
• Смешанные (литические и склеротические) изменения костей у пациента с инфекциями зубов или с «лункой» после экстракции зуба, в отсутствие данных о лучевой терапии в анамнезе
• Остеомиелит может обнаруживаться на фоне остеорадионекроза; эти два состояния часто бывает сложно дифференцировать
2. Бисфосфонатный остеонекроз:
• Изменения костной ткани смешанного (литического/склеротического) характера у пациента, получавшего лечение бисфосфонатами
• Данные о лучевой терапии в анамнезе отсутствуют
3. Плоскоклеточный рак альвеолярного гребня:
• Преимущественно деструктивные изменения костей и изъязвление слизистой
• Мягкотканное объемное образование, накапливающее контраст
• Остеорадионекроз в первую очередь нужно дифференцировать с рецидивом плоскоклеточного рака
4. Радиационно-индуцированная вторая первичная опухоль:
• Возникает спустя много лет (обычно >8) после лучевой терапии
• Чаще всего саркома, мягкотканное объемное образование

(Слева) При аксиальной КТ с КУ определяется остеорадионекроз нижней челюсти справа, осложненный инфицированием жевательного пространства. Определяется также нарушение целостности кортикальной пластинки и диффузный, выраженный отек жевательных мышц и околоушной слюнной железы, расширение ее выводного протока, заполненного дебрисом воспалительного характера.
(Справа) При МРТ Т1ВИ в корональной проекции определяется диффузное замещение сигнала, в норме наблюдающегося в костном мозге, и характерного для жира. Пристствуют множественные участки нарушения целостности кортикальной пластинки. Индурация и отек подкожных тканей являются часто встречающимися изменениями при остерадионекрозе нижней челюсти.
г) Патология:
1. Общая характеристика:
• Этиология:
о Ионизирующее излучение повреждает мелкие сосуды:
- Происходит разрушение эндотелиальной выстилки кровеносных сосудов, приводящее к обструктивной артериопатии
- Снижается способность костной ткани противостоять стрессам
о Остеорадионекроз часто провоцирует инфекция или травма, в т.ч. удаление зуба или биопсия
• Сопутствующие патологические изменения:
о В некротически измененной костной ткани часто присутствует бактериальная инфекция
- Считается, что остеомиелит не является первичным
- Остеорадионекроз часто сочетается с грам-положительной бактериальной инфекцией (актиномикозом)
2. Стадирование, классификация:
• Для стадирования и клинической градации используются различные системы
• Классификация Store и Boysen:
о Стадия 0: только дефекты слизистой оболочки
о Стадия I: рентгеновские признаки ОРН + интактная слизистая
о Стадия II: рентгеновские признаки ОРН + обнажение кости
о Стадия III: обнаженная кость с признаками остеорадионекроза + орокутанные фистулы
3. Макроскопические и хирургические особенности:
• Некроз и фрагментация кости с наличием секвестров и спикул
• Изъязвление слизистой оболочки с обнажением кости
4. Микроскопия:
• Некроз костной ткани, обусловленный преимущественно гипоксией:
о Облитерация артерий, в т.ч. нижней альвеолярной артерии, обусловленная лучевой терапией
• Гипоцеллюлярность костной ткани с нежизнеспособной надкостницей
• При исследовании биоптата могут обнаруживаться признаки остеонекроза, остеомиелита, рецидивной либо резидуальной опухоли
д) Клинические особенности:
1. Проявления:
• Типичные признаки/симптомы:
о Изъязвление кожи или слизистой оболочки с некрозом и обнажением кости у пациента, который ранее подвергался лучевой терапии (головы и шеи):
- Нижняя челюсть из костей лицевого черепа поражается чаще всего
- Возможно возникновение язв с обнажением кости
• Другие признаки/симптомы:
о Формирование свища, открывающегося в кожу
о Боль во рту, тризм, дизестезия, неприятный запах изо рта
о Инфицирование жевательного пространства, мелкие абсцессы
2. Демография:
• Эпидемиология:
о На заболеваемость ОРН влияют множество факторов:
- Опухоль: риск выше на третьей и четвертой стадии
- Планирование лучевой терапии: повышение риска связано с более высокой дозой, большим полем облучения, укорочением времени лечения
о Лучевая терапия с модулированной интенсивностью (ЛТМИ) способствует уменьшению лучевой нагрузки на кость и снижению заболеваемости ОРН:
- Лечение: риск повышается в связи с оперативным вмешательством (мандибулэктомия или иная остеотомия)
- Факторы риска, зависящие от пациента: повышение риска связано с недостаточной гигиеной полости рта, злоупотреблением алкоголем и табакокурением
3. Течение и прогноз:
• Заболеваемость ОРН • Пик заболеваемости: первые 6-12 месяцев после облучения
4. Лечение:
• Профилактика является наиболее значимым моментом перед лучевой терапией:
о Удаление зубов и санация периодонта до лучевой терапии
о Улучшение питания до и во время лечения
о Отказ от табака и алкоголя
• Консервативное лечение: антибиотикотерапия и местные ирригации
• Гипербарическая оксигенация для стимуляции ангиогенеза и как вспомогательный метод в лечении сочетанных инфекций:
о Перед осуществлением гипербарической оксигенации необходимо исключить резидуальную и рецидивную опухоль
• Секвестрэктомия и первичное закрытие раны на ранних стадиях заболевания
• Резекция кости и реконструктивное вмешательство при тяжелом прогрессирующем заболевании
е) Диагностическая памятка:
1. Следует учесть:
• Остеорадионекроз у пациентов, перенесших лучевую терапию, у которых вновь появилась боль, незаживающие язвы слизистой оболочки, литические/склеротические изменения костей (КТ)
• Необходимо исключить рецидив плоскоклеточного рака как источник боли и разрушения кортикальной пластинки:
о Мягкотканное образование позволяет склониться к опухоли
• Остерадионекроз может возникать спустя несколько лет после лечения; так, если после терапии прошло >8 лет, нужно исключать радиационно-индуцированную саркому, особенно, если обнаруживается мягкотканное образование
2. Советы по интерпретации изображений:
• Местная инфекция или патологический перелом
3. Рекомендации по отчетности:
• Распространенность поражения, нарушение целостности кортикального слоя, наличие спикул со стороны обнаженной кости, наличие секвестров
Рентгенограмма, КТ, МРТ при остеорадионекрозе челюсти
1. Аббревиатура:
• Остеонекроз (ОН) нижней и верхней челюсти
2. Синонимы:
• Лекарственно-обусловленный остеонекроз челюстей
• ОН челюстей, обусловленный применением бисфосфонатов
3. Определение:
• Некроз нижней или верхней челюсти, связанный с использованием лекарственных препаратов, чаще бисфосфонатов:
о Нарушение заживления, обнажение кости, сохраняющееся спустя 8 недель у пациента, не подвергавшегося облучению головы и лица
1. Общая характеристика:
• Лучший диагностический критерий:
о Деструктивные изменения смешанного (склеротического и литического) характера в месте экстракции зуба
• Локализация:
о Нижняя челюсть >> верхняя челюсть
о Поражение альвеолярного гребня, потеря зубов
о При запущенном течении патологический процесс распространяется на ветвь нижней челюсти
• Размер
о От фокуса до распространенной области деструкции кости
2. Рентгенологические данные:
• Рентгенография:
о Смешанные (пермеативные и склеротические) изменения, деструкция кортикальной пластинки и периостальная реакция
о Распространение литического процесса в канал нижнего альвеолярного нерва или патологический перелом в тяжелых случаях

(Слева) При аксиальной КТ в костном окне визуализируется очаг литического характера с нарушением целостности кортикальной пластинки нижней челюсти слева. Возле корней моляров нижней челюсти слева определяются участки «просветления». Изменения (незаживающая язва, обнажение кости, а также факт использования бисфосфонатов) позволяют сделать заключение об остеонекрозе.
(Справа) При аксиальной КТ в костном окне определяются типичные признаки остеонекроза нижней челюсти, обусловленного внутривенным введением бисфосфонатов. Обратите внимание на очаг смешанного (склеротического и литического характера) в теле нижней челюсти слева в месте недавней экстракции зуба.
3. КТ при остеонекрозе челюсти:
• КТ в костном окне:
о Ранние изменения: отсутствие заживления «лунки» после удаления зуба
о Поздние изменения: диффузная деструкция альвеолярного гребня
о Расширение пространства периодонтальной связки
о Возможен патологический перелом
о Отек мягких тканей в случаях тяжелой деструкции, инфицирования, патологического перелома
о После лечения возникает перманентный остеосклероз, новые литические изменения отсутствуют
4. МРТ при остеонекрозе челюсти:
• Т2ВИ:
о Изменения могут варьировать:
- В острой фазе: отек костной ткани с гиперинтенсивным сигналом
- В фазе заживления: сигнал различной интенсивности, в том числе гипоинтенсивный при наличии склеротических изменений
о Окружающие мягкие ткани, особенно жевательные мышцы, часто характеризуются сигналом высокой интенсивности, обусловленным отеком
о Реактивная ненекротическая лимфаденопатия I и II уровня
• ПВИС + FS:
о В процессе заживления в костях и окружающих мягких тканях часто происходит накопление контраста:
- Что не означает инфицирования или наличие опухоли
5. Рекомендации по визуализации:
• Лучший метод диагностики:
о Панорамная рентгенография зубов - первый метод визуализации, используемый для подтверждения диагноза
о КТ в костном окне, КТ с контрастным усилением при подозрении на присоединение инфекции
• Выбор протокола:
о КТ в костном окне с реформатированием в аксиальной и корональной плоскости для полной оценки распространенности поражения, а также потери зубов

(Слева) При МРТ Т1ВИ в аксиальной проекции у пациентки, находящейся на лечении бисфосфонатами по поводу рака молочной железы, с жалобами на боль в области челюсти, определяется отек нижней челюсти справа с сигналом низкой интенсивности, тогда как слева сигнал в коаном мозге не изменен. Определяется также перифокальное воспаление мягких тканей.
(Справа) Корональная КТ в костном окне, признаки тяжелого остеонекроза и дстарукции верхней челюсти у пациента с множественной миеломой (после внутривенного введения бисфосфонатов). Обратите внимание на костный секвестр. Определяется снижение пневматизации верхнечелюстной пазухи, которое, скорее всего, не связано с остеонекрозом.
в) Дифференциальная диагностика:
1. Остеомиелит нижней/верхней челюсти:
• Инфицированный зуб с поражением ближайших отделов нижней челюсти
• Периостальная реакция, кортикальный синусный тракт±абсцесс
2. Остеорадионекроз нижней/верхней челюсти:
• Данные о проводимой ранее лучевой терапии по поводу плоскоклеточного рака рта или ротоглотки
• Фокальные пермеативные изменения костей ± диссолюция (КТ)
3. Метастазы в нижней/верхней челюсти:
• Присутствует известная первичная опухоль
• Деструктивное мягкотканное новообразование нижней челюсти
1. Общая характеристика:
• Этиология:
о Остеонекроз связан с использованием новых лекарственных препаратов/бисфосфонатов с антирезорбтивными и антиангиогенными свойствами:
- Используются для лечения пациентов с метаболическими и онкологическими заболеваниями костей: болезнью Педжета, множественной миеломой, метастазами в костях
- Механизм действия: подавление активности остеокластов, уменьшение выраженности резорбции кости и остеолитических изменений
о Остеонекроз верхней или нижней челюсти может возникать спустя месяцы или годы после лечения
2. Макроскопические и хирургические особенности:
• Изъязвление слизистой оболочки рта, часто с обнажением нежизнеспособной кости
• Диагноз должен устанавливаться клинически, поскольку биопсия может усугубить течение заболевания
1. Проявления:
• Типичные признаки/симптомы:
о Боль в области челюстей и появление язв, расшатывание зубов, плохое заживление раны после экстракции зуба
• Другие признаки/симптомы:
о Острая и сильная боль: необходимо исключить патологический перелом
2. Течение и прогноз:
• Локальная санация, отмена лекарственных препаратов (бисфосфонатов) способствует прекращению прогрессирования процесса
• Остеонекроз является перманентным состоянием
3. Лечение:
• Отмена лекарственных препаратов, антибиотики при присоединении инфекции
• Хирургическая санация: удаление участков некроза, секвестров, разрушенной костной ткани
е) Список использованной литературы:
1. Bodem JP et al: Surgical management of bisphosphonate-related osteonecrosis of the jaw stages II and III. Oral Surg Oral Med Oral Pathol Oral Radiol. 121(4):367-72, 2016
2. Синонимы:
• Лучевой некроз, лучевой остеит
3. Определение:
• Гибель кости в результате лучевой терапии, не связанная с рецидивом опухоли
1. Общая характеристика:
• Лучший диагностический критерий:
о Прогрессирующие, плохо отграниченные литические изменения костей у пациента, ранее получавшего лучевую терапию
• Локализация:
о Нижняя: верхняя челюсть=24:1; часто задние отделы нижней челюсти
о Ранее травмированный участок (после удаления зуба; язвы слизистой оболочки, обусловленные зубными протезами)
(Слева) На кадрированной панорамной рентгенограмме определяется ОРН в области удаленного третьего моляра. Картина изменений костной ткани смешанная, и включает в себя литический и склеротический компоненты с наличием секвестра. Симптом ступеньки на нижней кортикальной пластинке позволяет предположить патологический перелом.
(Справа) На аксиальной КТ с КУ в костном окне у этого же пациента четче определяются изменения нижней челюсти справа в виде разрежения трабекулярной кости и деструкции кортикальных пластинок. Оаатки кортикальных пластинок секвестрированы. (Слева) На корональной КТ в костном окне у этого же пациента отчетливо определяется фрагментация щечной и язычной кортикальных плааинок наряду с разрежением трабекулярной костной ткани нижней челюсти справа. Также определяется склероз оставшейся губчатой кости.
(Справа) На аксиальной КТ в костном окне у этого же пациента краниальнее определятся более легкие изменения, обусловленные ОРН. Определяется деарукция щечной кортикальной пластинки на уровне нижнечелюстного отверстия. (Слева) На аксиальной КТ с КУ у этого же пациента определяется минимальное утолщение мягких тканей. Уплотнение подкожного жира, утолщение кожи и повышение плотноаи жировых пластинок являются постлучевыми изменениями.
(Справа) На кадрированной панорамной рентгенограмме у этого же пациента-состояние после тотальной резекции и реконструкции нижней челюсти справа. Это пример радикального лечения, предпринятого по поводу ОРН.
2. Рентгенография при остеорадионекрозе челюсти:
• Деструкция кости в сочетании с остеосклерозом
• Незаживающий дефект после удаления зуба или мандибулотомии
• Деструкция кортикальных пластинок и патологический перелом
• Рентгеновские признаки ОРН могут обнаруживаться в отсутствие изъязвления кожи или слизистой оболочки
• Расширение пространств периодонтальной связки после лучевой терапии позволяет отнести кость к «зоне риска»
3. КТ при остеорадионекрозе челюсти:
• Оценка локализациии литических изменений и эрозий кортикальных пластинок
• Визуализация склеротических изменений вокруг зоны разрежения кости
• Более четкая идентификация секвестров и переломов
• Возможно утолщение мягких тканей возле патологического очага в кости, особенно в случае воспаления
• Периостальные наслоения нетипичны
4. МРТ при остеорадионекрозе челюсти:
• Т1ВИ:
о Однородный гипоинтенсивный сигнал в костном мозге вследствие фиброза
• Т2ВИ:
о Вариабельный гиперинтенсивный сигнал в костном мозге (воспаление)
о Возможен гиперинтенсивный сигнал в соседних мышцах
• Т1ВИ С+FS:
о Легкое или умеренное неравномерное накопление контраста в пораженных костях и мягких тканях
5. Рекомендации по визуализации:
• Лучший метод визуализации:
о Панорамная рентгенография эффективна для мониторинга после лучевой терапии
о КТ-лучший метод оценки изменений костей:
- Необходим для исключения рецидива злокачественной опухоли
(Слева) На кадрированной панорамной рентгенограмме определяется ОРН в задних отделах нижней челюсти справа после удаления моляра. Выраженная деструкция костной ткани привела к патологическому перелому. Также определяется склероз окружающей костной ткани с наличием секвестра.
(Справа) На аксиальной КТ с КУ в костном окне у этого же пациента определяется патологический перелом нижней челюсти справа с захождением отломков на фоне ОРН. В губчатой кости также визуализируется маленький секвестр. (Слева) На кадрированной панорамной рентгенограмме у этого же пациента 14 месяцев спустя определяется разрешение патологических изменений в нижней челюсти. Имеет место резорбция костной ткани мезиальнее моляра верхней челюсти с разрушением дна верхнечелюстной пазухи, подозрительная на ОРН.
(Справа) На аксиальной КТ с КУ в костном окне у этого же пациента определяется ОРН с поражением нижней челюсти справа. Определяется также деструкция щечной и небной кортикальных пластинок и склероз бугристости верхней челюсти. (Слева) На корональной МРТ (Т1ВИ) у этого же пациента определяется гипоинтенсивный сигнал в костном мозге нижней челюсти справа, обусловленный фиброзом в связи с ОРН. Обратите внимание на нормальный «жировой» сигнал в костном мозге нижней челюсти слева.
(Справа) На корональной MPT (Т2 ВИ FSE) у этого же пациента определяется умеренно интенсивный сигнал в костном мозге нижней челюсти справа, пораженной ОРН. Определяется также легкое повышение интенсивности сигнала в окружающих мягких тканях. Эти изменения также обусловлены вторичным воспалением.
1. Рецидив злокачественной опухоли:
• Более вероятна мягкотканная опухоль, а не склероз
• Изменения костей вдали от первичной опухоли, но в поле облучения, позволяют исключить рецидив злокачественного новообразования
2. Лекарственно-индуцированный остеонекроз:
• Прием антирезорбтивных препаратов (бисфосфонаты, деносумаб) в анамнезе, а не лучевая терапия
3. Остеомиелит:
• Отсутствие данных о лучевой терапии в анамнезе
• Симптоматика: лихорадка, лимфаденопатия, отсутствие обнажения кости
1. Общая характеристика:
• Этиология:
о Теория фиброза и атрофии: фиброз, каскад воспалительных реакций, нарушение заживления
2. Микроскопия:
• Некроз кости с наличием лакун, не заполненных остеоцитами; отсутствие остеобластов и вновь образованного остеоида
1. Проявления:
• Типичные признаки/симптомы:
о Дефект кожи или слизистой оболочки с обнажением подлежащей кости > 3 месяцев
о Часто (но необязательно) возникает боль
о Вторичная инфекция с гнойным отделяемым, вожможно формирование наружных свищей
2. Демография:
• Эпидемиология:
о 2-15% пациентов, подвергшихся лучевой терапии головы и шеи
3. Течение и прогноз:
• Заболевание часто дебютирует через 4 месяца - 3 года после облучения
• Факторы риска:
о Факторы терапии: доза (> 60 Гр), частота, поле, технология облучения (ЛТМИ = 1 риск)
о Факторы опухоли: размер, расположение, вовлечение кости о факторы пациента: инфекционные поражения зубов, травма, злоупотребление алкоголем или табаком, нарушение иммунитета
4. Лечение остеорадионекроза челюсти:
• Лечение зубов перед лучевой терапией позволяет избежать удаления зубов после облучения
• Консервативное: санация, антибиотики, ирригации
• Хирургическое: секвестрэктомия, тотальная резекция с реконструкцией в случаях, тяжело поддающихся лечению
• Изучается возможность применения гипербарической оксигенотерапии, антифибротических, антиоксидантных средств и бисфосфонатов
1. Советы по интерпретации изображений:
• Прогрессирующая деструкция кости и остеосклероз в зоне облучения подозрительны на ОРН
2. Заключение:
• Абсолютно необходимо исключить рецидив злокачественной опухоли
ж) Список использованной литературы:
1. Obinata К et al: Image findings of bisphosphonate related osteonecrosis of jaws comparing with osteoradionecrosis. Dentomaxillofac Radiol. 20160281, 2017
КТ и МРТ при дисфункции височно-челюстного сустава - что лучше покажет

Ведущим методом выявления патологических изменений в височно-нижнечелюстного сустава (ВНЧС) при различных видах поражения является лучевая диагностика:
Рентгенография и КТ дает возможность своевременно выявлять разнообразные патологии костей, зубов и челюсти. Однако следует отметить, что традиционные рентгенологические методики исследования в условиях естественной контрастности оказались малоинформативными в силу того, что наибольшую часть среди поражений ВНЧС занимают патологические изменения в его мягкотканных элементах (гнойные поражения нижней челюсти, кисты, флюсы, артрозы, некрозы). Визуализация данных патологий потребует проведения магнитно-резонансной томографии ВНЧС.
Что лучше выбрать для первичной диагностики височно-нижнечелюстного сустава?
Если у Вас стали возникать проблемы с закрытием рта, появился инородный звук при движении челюстью, есть неприятные ощущения в челюстных суставах, следует обратиться к челюстно-лицевому хирургу. Многие пациенты не уделяют должного внимания вышеперечисленным симптомам, считая их незначительными. Между тем, практически все эти симптомы говорят о возможном наличии серьезной патологии – дисфункции височно-нижнечелюстного сустава. К сожалению, медицинские специалисты вынуждены отметить, что слишком часто больные обращаются за медицинской помощью тогда, когда незначительные на первых порах симптомы уже развиваются в тяжелое заболевание, которое проявляется в невозможности пережевывать пищу из-за сильной боли и дискомфорта, смещении в сторону нижней челюсти, неправильных, зигзагообразных движениях челюсти при открывании рта. Подобные запущенные состояния лечить достаточно сложно. В некоторых случаях по результатам диагностики уже приходится прибегнуть к оперативному вмешательству, которого можно было бы избежать при своевременном прохождении томографии височно-челюстного сустава или КТ челюсти.
Часто компьютерная томография и МРТ суставов назначаются после того, как было проведено первичное рентгенологическое исследование. Если на полученных снимках лечащий врач обнаруживает подозрительную по его мнению зону, то дальше последует назначение на МРТ или КТ, которое позволят детально рассмотреть проблемный участок и поставить безошибочный диагноз.
Что входит в МРТ височно-нижнечелюстного сустава
В стандартный протокол МРТ височно-нижнечелюстного сустава входит обследование следующих структур:
- головка мыщелкового отростка
- нижней челюсти
- височная кость
- суставная щель
- костный мозг
- суставной диск
- видимые отделы околоносовых синусов.
Что входит в МСКТ челюсти
В стандартный протокол КТ челюсти входит обследование следующих структур:
КТ верхней челюсти
- адентия зуба
- лунка зуба
- альвеолярный отросток
- зубы
- шейка зуба
- периодонтальные щели
- парадонтальный карман
- слизистая оболочка
- правая верхнечелюстная пазуха
- жидкость в полости пазухи
- верхнечелюстная пазуха,
КТ нижней челюсти
- адентия зуба
- лунка зуба
- плотность кости
- альвеолярный отросток
- канал корня
- парадонтальный карман.
Диагностика дисфункции височно-челюстного сустава на КТ и МРТ
По статистике, дисфункция ВНЧС встречается в 80-85% случаев заболеваний челюсти. Наиболее частыми причинами, вызывающими эту болезнь, являются нарушения прикуса (в том числе, и по вине врачей-протезистов), сильное однократное перенапряжение жевательных мышц (например, при попытке откусить твердую еду), слишком высоко выступающая пломба на зубе, непроизвольный спазм челюстно-лицевых мышц при сильных физических нагрузках и стрессах. Все это способно нарушить синхронность работы височно-нижнечелюстных суставов. Также односторонние нагрузки на челюсть, когда по разным причинам приходится жевать только какой-то одной стороной челюсти, неизбежно приводят к смещению дисков и нарушению их правильного функционирования, сопровождающегося сильным болевым синдромом.
В медицинских центрах диагностика дисфункции височно-нижнечелюстного сустава осуществляется с помощью:
Пациентам с дисфункцией височно-челюстного сустава для уточнения характера дислокации суставного диска диагностику следует начинать с проведения МРТ, для уточнения степени вторичных изменений сустава дегенеративного характера целесообразно дополнительно использовать компьютерную томографию.
Что лучше - КТ или МРТ височно-нижнечелюстного сустава?
Однозначного ответа на это вопрос нет. Магнитно-резонансный томограф очень схож с аппаратом компьютерной томографии, но эти два вида диагностики отличаются по своим физическим принципам. При КТ аппарат задействует Х-лучи, и именно с помощью этих лучей и получаются снимки. МРТ аппарат не несет лучевую нагрузку, поскольку работает за счет эффекта резонанса магнитного поля.
В общем и целом, магнитно-резонансная томография позволяет рассмотреть любые отклонения от нормы в мягких тканях и хрящах, а КТ хорошо отображает костные структуры. Комбинированное применение этих двух методов томографии дает возможность врачам выявлять мельчайшие аномалии челюстных суставов в стадии их зарождения и оценить состояние соседних мягких структур.
| МРТ височно-челюстного сустава | КТ височно-челюстного сустава |
Так, пациентам с механическими повреждениями ВНЧС диагностику следует начинать с КТ для выявления патологических изменений костных элементов. Компьютерная томография позволяет установить зависимость характера дислокации обломков от локализации перелома, а при внутренних нарушениях - оценить тяжесть поражения костных структур за счет присоединения остеоартроза. При ревматоидном артрите компьютерная томография обеспечивает визуализацию протяженности и степени выраженности эрозивных и литических повреждений суставных поверхностей. Последующее использование МРТ показано при необходимости установления характера повреждения мягкотканных структур сустава. Магнитно-резонансная томография поможет определить характер дислокации суставного диска и его взаимоотношения с головкой нижней челюсти, разрыв диска и внутрисуставных связок, а также обнаружить гемартроз и синовит.
При артрите и артрозе необходимо одновременное комплексное применение МРТ и КТ для визуализации синовита, изменения суставного диска, а также для определения степени выраженности патологических изменений суставных поверхностей.
Противопоказания к МРТ
При МРТ исследовании на пациента действует магнитное поле, и все абсолютные противопоказания будут связаны с этим фактом:
Магнитное поле может привести в движение объекты, которым свойственно с ним взаимодействовать, это могут быть: клипсы на сосудах, металлоконструкции в любом участке тела. Поэтому если в организме установлен имплант, пациенту нужно будет предъявить документы, в которых указан состав материала. В случае, если это неферромагнитный материал (например, титан), проведение МРТ разрешено.
Магнитное поле может повлиять на работу электронных устройств: электокардиостимуляторы, инсулиновые помпы, слуховые протезы. Если в паспорте импланта не указано, что он совместим с МРТ, необходимо подобрать альтернативный метод диагностики.
Следует отметить, что иногда проведение МРТ не возможно в следующих случаях:
- вес пациента выше максимально допустимых параметров для конкретного аппарата (стол современного томографа чаще всего выдерживает вес до 120 кг);
- габариты пациента выше максимально допустимой величины для конкретного аппарата (современные магнитно-резонасные томографы чаще всего имеют диаметр трубы 60-70 см);
- у пациента сильная форма клаустрофобии;
- пациент не может сохранять неподвижность во время обследования.
Противопоказания к КТ
При КТ исследовании основным значимым фактором риска является наличие лучевой нагрузки на организм пациента. Она может варьироваться в зависимости от зоны сканирования, модели аппарата и протокола сканирования. Но она есть всегда. Поэтому:
КТ исследование не проводят беременным женщинам на любом сроке вынашивания.
Детям до 5 лет не желательно делать КТ, за исключение ситуации, где это необходимо по жизненным показаниям.
Следует отметить что иногда проведение КТ невозможно в следующих случаях:
Рентген, МРТ или КТ челюсти - отличия исследований
Для обследования челюсти в арсенале врачей есть ряд аппаратных форм диагностики:
Каждый из видов обследования имеет свои преимущества, сильные и слабые стороны. В этой статье мы более детально разберем вопрос, что и когда лучше выбирать - МРТ, КТ или рентген челюсти.
Основное отличие рентгена, МРТ и КТ верхней и нижней челюсти заключается в способе получения изображения. КТ исследование и рентген - это рентгенологические обследования. Физика получения изображения здесь строится на использовании способности Rg лучей с разной скоростью проходить и задерживаться в тканях разной плотности. В магнитно-резонансной томографии принцип визуализации основывается на явлении ядерного магнитного резонанса, когда атомы водорода в клетках тканей под воздействием электромагнитного поля начинают совершать колебательные движения. Этот резонанс улавливает компьютер томографа, оцифровывает и строит трехмерные изображения тканей.
Отличия МРТ и КТ челюсти
КТ зубов и челюсти является приоритетной формой диагностики костей, поскольку в костных тканях рентгеновские лучи задерживаются в большем объеме. Если перед врачом стоит диагностическая задача оценить структуру зубов и челюсти, он выберет рентгенологические метод диагностики. КТ челюсти хорошо покажет травматические повреждения костей лица, остеонекроз, остеоартроз, остеоартрит, остеомиелит. МРТ челюсти фокусируется на качественной визуализации мягких тканей и состояния височно-нижнечелюстного сустава. С ее помощью можно хорошо оценить воспаления суставных тканей, дисфункции ВНЧС, новообразования. Поскольку в костных структурах содержится мало воды, добиться хорошего резонанса в них сложно, поэтому кости на МРТ снимках отображаются с наименьшей точностью.
Чем КТ челюсти лучше рентгена
КТ челюсти и рентген строят визуализацию на одном и том же принципе, однако точность обследования и уровень детализации на компьютерной томографии в разы выше, чем на рентгенограммах. В ходе рентгена челюсти аппарат посылает пучки рентгеновского излучения из одной точки. В результате есть возможность создать двухмерные изображения, на которых органы и структур накладываются друг на друга. Это снижает диагностическую точность исследования. В компьютерном томографе рентгеновские лучи посылаются несколькими излучателями, которые движутся по периметру кольца гентри. За счет такого конструктивного решения есть возможность получить множественные снимки исследуемых сегментов под разными ракурсами и на базе них выстроить детальную трехмерную объемную реконструкцию.
Когда назначают панорамное 3d КТ челюсти
Иногда пациент может запутаться в различиях в ряде рентгенологических обследований, которые назначают в стоматологии:
- панорамный снимки зубов;
- КТ зубов;
- 3d КТ обеих челюстей.
Панорамный снимок зубов или ортопантомограмма – это рентгенологическое обследование. С ее помощью врачи получают двухмерные изображения корней зубов. Данный вид диагностики чаще всего применяют при лечении сложных кариесов, протезировании, планировании имплантации.
КТ 3D снимок зубов выполняется на специальном аппарате, называемом конусно-лучевым компьютерным томографом. Конусно-лучевой компьютерный томограф (КЛКТ) представляет собой один из видов КТ оборудования, при котором выполняются множественные послойные снимки низкодозированным рентгеновским облучением в различных плоскостях. Преимущество 3D снимка зубов в получении изображения без искажений, а так же возможности детализированного просмотра зубов со всех сторон в трехмерной проекции.
КТ челюсти - это обследование на мультиспиральном компьютерном томографе (МСКТ). Задача этого сканирования в отображении состояния верхней и нижней челюсти, зубов, гайморовых пазух, челюстных суставов и прилегающих мягких тканей.
панорамный снимок зубов
Как делают КТ челюсти
КТ челюсти обычно проводят по направлению врача стоматолога, хирурга или ортопеда-травматолога. В клиниках ее могут осуществлять по следующим протоколам:
- КТ двух челюстей
- КТ верхней челюсти
- КТ нижней челюсти
- КТ челюсти с контрастом
Сделать данное обследование можно как взрослым, так и детям. Поскольку компьютерная томография сопряжена с лучевой нагрузкой, ее стараются не осуществлять детям до 3 лет. В более старшем возрасте ребенку это исследование проводят только при наличии направления от лечащего врача и не чаще одно раза в год. Взрослым пациентам компьютерное сканирование можно сделать как по личной инициативе, так и по направлению врача. Не осуществляют КТ только при беременности. Из-за лучевого облучения КТ во время вынашивания младенца опасно делать на любом сроке. Облучение вредно для здоровья малыша, поскольку может вызывать необратимые мутации и стать причиной выкидыша или замершей беременности.
Лучевая нагрузка при КТ челюсти
Уровень лучевой нагрузки на организм пациента при КТ челюсти зависит от:
В большинстве медицинских центрах Санкт-Петербурга такое сканирование осуществляют на мультиспиральных компьютерных томографах со срезовой мощностью не менее 16 срезов. Средняя доза облучения составляет 1-3 мЗв за сеанс сканирования.

- Винерский П.М. Профилактика осложнений при лечении переломов нижней челюсти в области угла // Стоматология: Респ. сб. Киев, 1990.-Вып.25. - С.70-72.
- Григорьянц А. A. Патогенез, диагностика и лечение гнойно-воспалительных осложнений при сочетанной челюстно-лицевой и черепно-мозговой травме (клинико-иммунологические и иммуногенетические аспекты): Дис. д-ра мед. наук. М, 1992. - 48 с.
- Гюльназарова С.В., Казак Л.А., Машинская Т.М. // Травматология, ортопедия, протезирование. 1991. - № 9. - С.21 -23.
- Кокоткина А.С. Особенности клиники и лечения больных с переломами нижней челюсти при пародонтозе: Автореф. дис. канд. мед. наук. -М., 1969.
- Колмакова А.А. Наружный внеочаговый компрессионный остео-синтез при переломах нижней челюсти (Экспериментально-клиническое исследование): Дис. .д-ра мед. наук. Ростов-на Дону, 1970. - 401 с.
- Кравцова Г.Н. Лечение больных с переломами нижней челюсти, осложненными травматическим остеомиелитом: Автореф. дисс. . канд. мед. наук. Омск, 1993. - 19 с.
- Оноприенко Г.А. Васкуляризация костей при переломах и дефектах. М: Медицина, 1995. - 220 с.
- Рабухина Н.А. Рентгенодиагностика некоторых заболеваний зубо-челюстной системы. М.'Медицина, 1974. 280 с.
- Рентгенодиагностика заболеваний челюстно-лицевой области: Руководство для врачей / Под ред. Н.А. Рабухиной, Н.М. Чупрыниной. М.: Медицина, 1991. - 368 с.
- Чудаков О.П., Бармуцкая А.З. Лечение травматических переломов нижней челюсти, осложненных травматическими остеомиелитами // 1-й Белорусский междунар. конгр. хирургов. Витебск, 1996. - С. 127-129.
Информационные статьи о диагностике

КТ челюсти (альтернативное название КТ верхней и нижней челюсти, КТ челюсти и гайморовых пазух, КТ зубов и челюсти) - это рентгенологическое обследование. Делают КТ двух челюстей обычно с использованием современного мультиспирального томографа со срезовыми возможности 16 срезов и выше.
При подозрении на коронавирус могут назначить сделать КТ легких. Стоит сразу сказать, что КТ при COVID-19 проводится не в поточном порядке. Томографию целесообразно применять в ситуации, когда заболевание развивается с осложнениями в виде воспаления легких. Легкая форма коронавируса обычно проходит без признаков пневмонии, и делать компьютерную томографию при таком течении болезни не целесообразно.

КТ и МРТ височно-челюстного сустава дает возможность своевременно выявлять разнообразные патологии костей, зубов и суставных тканей этой части челюсти. К таким болезням относят: остеомиелит, гнойные поражения нижней челюсти, флюсы, артрозы, некрозы. Если у Вас стали возникать проблемы с закрытием рта, появился инородный звук при движении челюстью, есть неприятные ощущения в челюстных суставах, следует обратиться к челюстно-
Читайте также:
